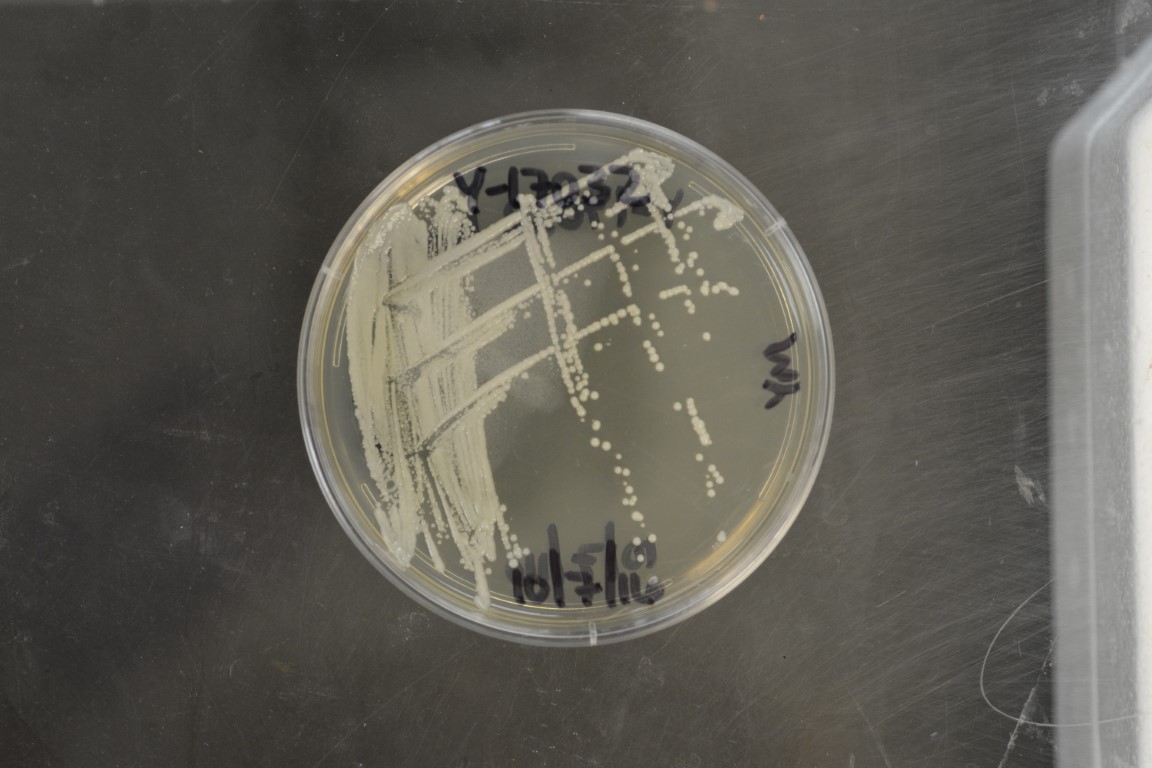

Candida mogii
NRRL Y-17032(Type Strain)
Accession numbers in other collections:AJ 5141=ATCC 18364=ATCC 60124=CBS 2032=CCRC 22402=DBVPG 6146=IAM 4979=IFO 0436=IGC 3688=JCM 1611=NRRL Y-17062
Source:D.Yarrow,CBS,Delft,The Netherlands
Isolated from(substrate):FFD,fuchu miso
Substrate location:Japan
Genetic info:Robnett PCR#402.GenBank:D1/D2(U44820).
Growth media:Yeast Extract-Malt Extract-Peptone-Glucose(YM for yeasts)(number 6)
Optimum growth temperature:25C
Strain images:
NRRL_Y-17032_6.JPG

Comments:type strain of Candida mogii,Metschnikowia clade